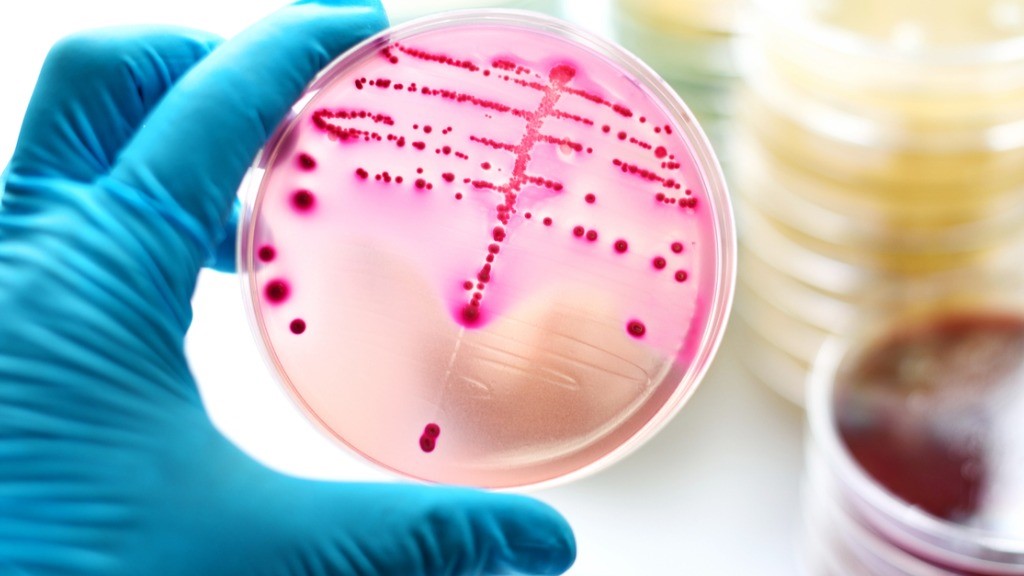
Scientist with bacteria on agar plate

New and exciting research is constantly emerging about gut health, as science reveals more about the mysterious world of microorganisms in the microbiome. ‘Probiotics’ and ‘prebiotics’ are now commonplace terms for most people (you can learn more about probiotics and prebiotics on the Probiotics Learning Lab); however, you may not be so familiar with latest addition to the probiotic family, ‘postbiotics’. But what are postbiotics? What do postbiotics do? There is much confusion regarding this newcomer to the category, but this article aims to provide some clarity. Read on for the definitive guide to postbiotics…
What are postbiotics?
In simple terms, as currently offered by many informational sites on the subject, postbiotics are the bio-active by-products created by probiotic bacteria in the gut when they ferment prebiotic fibres1. However, this simplified explanation is not strictly true - this new category represents a confusing messy field with varied terminology within the industry, and clarification is still needed on definitions and agreed terms.
There is an official definition, published by the International Scientific Association for Probiotics and Prebiotics (ISAPP), which has agreed that a postbiotic is “a preparation of inanimate microorganisms and/or their components that confers a health benefit on the host”2.
‘Inanimate organisms’, in this case, are heat-killed bacteria, also known as non-viable probiotics, para-probiotics, ghost-biotics, and heat-inactivated probiotics3, though it is the bacterial metabolites which seem to be the more commonly accepted definition of the term ‘postbiotics’ at this time.
Postbiotic - a preparation of inanimate microorganisms and/or their components that confers a health benefit on the host
This is still a developing area of research, and there is still justifiable confusion and a lack of consensus regarding the true definition of postbiotics and which compounds should be included as part of the definition. An ongoing debate is conflicted over whether postbiotics are lysates, metabolites, cell wall components, or just heat-killed bacteria, but key words in the ISAPP definition help to provide some clarity2:
‘Inanimate’ – bacterial cells which have been ‘killed’
‘Microorganism’ – that is, must contain whole or broken microbial cells
‘Components’ – cells with or without metabolites, but NOT the metabolites alone
‘Confers health benefit on the host’ – anything classed as a postbiotic needs scientific evidence to support this
It’s worth noting that true post-biotic inanimate microorganisms must be specifically 'de-activated' (typically heat-killed) and not just naturally deceased bacteria, as the process must be deemed to be replicable.
What is the difference between prebiotics, probiotics, synbiotics, and postbiotics?
These terms seem very similar and quite confusing but if we look at them in stages, then they begin to make more sense:
Prebiotics – this term relates to the food sources favoured by probiotic bacteria, typically fibres which are indigestible to humans but which are fermented by the probiotic bacteria in the gut microbiome.
Probiotics – ‘probiotic’ means ‘for health’. Probiotics are bacteria which live in our bodies and confer a health benefit on their host.
Synbiotics – this is the term given to a supplement which contains both probiotics and prebiotics.
Postbiotics – finally, postbiotics are the end-products of probiotic bacteria, as inanimate bacterial cells and bacterial metabolites.
For now, the huge weight of clinical evidence supporting the use of probiotics and prebiotics means they are still the go-to supplement for most practitioners, but research is constantly evolving and postbiotics are an exciting new area to watch.
For more information about probiotics, prebiotics, and synbiotics, read these articles on the Probiotics Learning Lab:
What are Probiotics?
What are Prebiotics?
What are Synbiotics?
Examples of bacterial metabolites4,5:
Vitamins/amino acids
GABA, dopamine, and other neurotransmitters
Organic acids
Cell wall repair
Quorum sensing molecules (signalling molecules used for cell–cell communication between bacteria, which allow bacteria to share information)
Peptides
Proteins
Enzymes
Exopolysaccharide (long-chain polymers of sugars and carbohydrates excreted by bacteria and other micro-organisms)
Bacteriocins
SCFAs – short-chain fatty acids such as butyrate
Other by-products which are as yet unknown
It should be noted, however, that whilst end products like SCFAs acid fit in to this list as metabolites, according to the ISAPP definition of postbiotics, they are not classed as postbiotics in their own right, Therefore if presented alone as supplements in a purified form and in the absence of cellular biomass (e.g a heat-killed micro-organism) they should be labelled with their chemical name, e.g. ‘butyric acid’, and not as post-biotics.
What do postbiotics do?
There’s great excitement over the potential of postbiotics for health, but the first thing to understand is that this is an area of research still in its early stages of development. Regulators are still cautious about the category, and at this point in time, the degree of interest in postbiotics far outweighs the supporting evidence so far.
For example, the word ‘probiotics’ is considered to be a health claim – as stated, it means ‘for health’, and to be classified as probiotic microorganisms must have demonstrated a health benefit. Similarly, in order to be classed as an effective postbiotic, the inactivated microbial cells, with or without metabolites, must be shown to offer health benefits2.
Visit the Probiotics Learning Lab to discover more about the Benefits of Probiotics.
5 health benefits of postbiotics
Postbiotics may be considered to have different benefits to probiotics, though there will be some overlap. Positive benefits which may be expected from postbiotics fit broadly into the following areas2,4:
Immune system6
Diversity of gut microbiome7
Inflammatory response8
Healthy mucosal lining9
Impact on nervous system and metabolic response2
There may be some advantages of using postbiotics (heat-killed bacteria) over probiotics for the following reasons:
They may be a better choice for immune-compromised people rather than taking live bacteria
They can be used in different formats (e.g. heated products) which live probiotics could not survive
Research shows that postbiotics are even better at protecting against diversity loss when used with antibiotics6
There are also some specific strains of probiotics which are particularly good at defending the microbiome against diversity loss – read more about Taking Probiotics with Antibiotics on the Probiotics Learning Lab.
Which foods are postbiotics?
Potentially, all fermented foods may contain postbiotics in the form of metabolites from the fermentation process. Exactly which compounds are present may be difficult to determine, as often the bacteria present in cultured foods are difficult to determine. Again, if we are using the ISAPP definition as our guide, then merely containing the by-products of fermentation does not define fermented foods as postbiotics. The numbers and strains of bacteria found in fermented products like kombucha (or kefir, kimchi etc.) are notoriously difficult to define and quantify, and the definition states that something cannot be considered to be a postbiotic if it isn’t made using defined microorganisms:
“To qualify as a postbiotic, the microbial composition prior to inactivation must be characterized, and so preparations derived from undefined microorganisms are not included in the definition. For example, many traditional fermented foods are made through the action of undefined, mixed cultures, and such a product could not be used for the preparation of a postbiotic. However, postbiotics could be derived from fermented products made using defined microorganisms.”2
But certain foods are thought to particularly encourage the production of useful by-products in the gut, including foods containing prebiotic fibres like oats, flaxseed and garlic; buttermilk, cottage cheese, fermented pickles such as kimchi, and yogurts10.
Read Dr. Aisling’s article about the Uses of Prebiotics to find out why these are such important additions to the diet.

Certain foods, such as fermented foods, can encourage the production of useful by-products in the gut
Can you take postbiotics and probiotics together?
There is no reason why you can’t take postbiotics with probiotics, but if you’re taking a probiotic supplement then you will naturally be encouraging bacterial colonies and should benefit from a supply of postbiotic metabolites. Postbiotic supplements, however, should ideally, according to the ISAPP definition, contain a combination of heat-killed bacteria and bio-active end products.
Where do you get postbiotics?
Regulators are still trying to ascertain where these substances fit into the health marketplace, and consequently, specialist probiotic supplement companies may hesitate before jumping on the postbiotic bandwagon. As mentioned, there is a lot of hype around the subject, and this may be getting ahead of the science at this stage. There is still much more research to be done, both in terms of what constitutes a postbiotic, and also which potential benefits they may have when taken as a supplement rather than occurring naturally in the gut (in respect of metabolites). Postbiotic supplements are also difficult to quantify – depending on the ingredients, supplements may be offered either in mg or CFUs like probiotics (CFU relating to the original number of viable organisms prior to heat treatment).
However, despite the research and true definition still being in the preliminary stages, in the global marketplace there are already around 100 supplements labelled as pure postbiotics available4, mostly in Japan and Korea, followed by the USA, and 150 combination products containing postbiotics. The UK postbiotics market is a little slower to catch up, but trusted UK probiotic companies will want to ensure that the supporting evidence is solid before adding postbiotics products to their ranges.
Postbiotic compounds may also be found in skincare and cosmetics, for example, in the form of collagen produced by bacteria. ‘Postbiotic’ skincare products are actually nothing new in the field of dermatology, as skincare products often contain bacterial by-products such as lactic acid, though as we’ve learned, these may not strictly be called postbiotics in their own right.
Who should not take postbiotics?
As this is still an emerging area in the probiotics research sector, no specific contraindications have been agreed for postbiotics. In terms of metabolites, the postbiotics category is vague and broad, so may include a wide range of compounds.
In terms of heat-killed bacteria as postbiotics: it is thought that these may be a safer choice for immune-compromised people rather than taking live bacteria, which may be contraindicated in those who are immune-compromised or have a serious health condition.
Key Takeaways
Terminology: there is still some confusion over when something becomes a postbiotic and education is this field is still evolving. Currently the term postbiotics encompasses heat-killed bacteria and bacterial metabolites
Benefits: the available science is convincing for postbiotics and indicates their potential for health, but there may be a time and place for their use, and sometimes live probiotics might be more appropriate.
Postbiotic supplements: there are already a number of postbiotic supplements available, but there is still some caution being exercised over the development of these products.
If you enjoyed this article, you may also enjoy these other recent articles:
Could probiotics help with weight loss?
Probiotics and C. difficile










